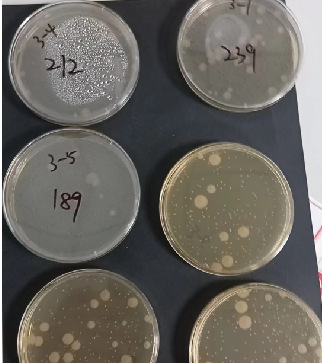
1701685016152

Автоклав для стерилизации паром при высокой температуре, ампула с биологическим индикатором
Цена
¥1200.00 / ≈ 14 455 ₽
MOQ: 100 pcs
100шт - ¥1200.00
Продавец
安徽李斯特医疗科技有限公司
Рейтинг
0
Продано
0
Всего
В наличии
500000
SKU суммарно
Offer ID: 758199746772
Статистика продавца
4.0
Сервис
Источник: API 1688
3.0
Логистика
Источник: API 1688
4.0
Споры
Источник: API 1688
3.0
Оформление
Источник: API 1688
5.0
Консультация
Источник: API 1688
0%
Повторные покупки
Источник: API 1688
3.3
Постпродажное
Источник: API 1688
Свойства товара
Название продукта High temperature steam sterilization self-contained steam sterilization biological indicator ampoule
Код продукта Lbs144-6
Внешний вид Tubular
Категория Preparation excipients
Спецификация Lbs144-6, lbs144-5
Стандарт качества Iso11138-1
Основное применение Sterilization process validation and routine monitoring of moist heat
Срок годности 24
Описание товара
高温蒸汽灭菌自含式蒸汽灭菌生物指示剂安瓿瓶
LISTERA系列产品是一个安瓿式的自含式生物指示剂,用于监测容器或灭菌器内液体蒸汽灭菌的效力。
LISTERA安瓿式生物指示剂含有售热脂肪地芽孢杆菌芽泡和一种特殊配方的培养基。如果芽孢生长,培养基就会变成亮黄色。
LISTERA使用简便,在24小时内即可通过肉眼观察到灭菌结果,无需困难又耗时的实验室操作。
LISTERA 优点:
- 24小时内显示结果
- 小(1mD而方便的安瓿)
- 可下沉于溶液
- 每盒均包含阴性对照
- 不需要实验室
- 颜色显著变化
- 李斯特独有的微生物培养:
存储
2-8°C冷藏。
认证
生物指示剂用了可溯源的菌种,并通过了含菌量、D值、z值、Fo值和性能的认证。
国产研发,厂家直销

高温蒸汽灭菌自含式蒸汽灭菌生物指示剂安瓿瓶
